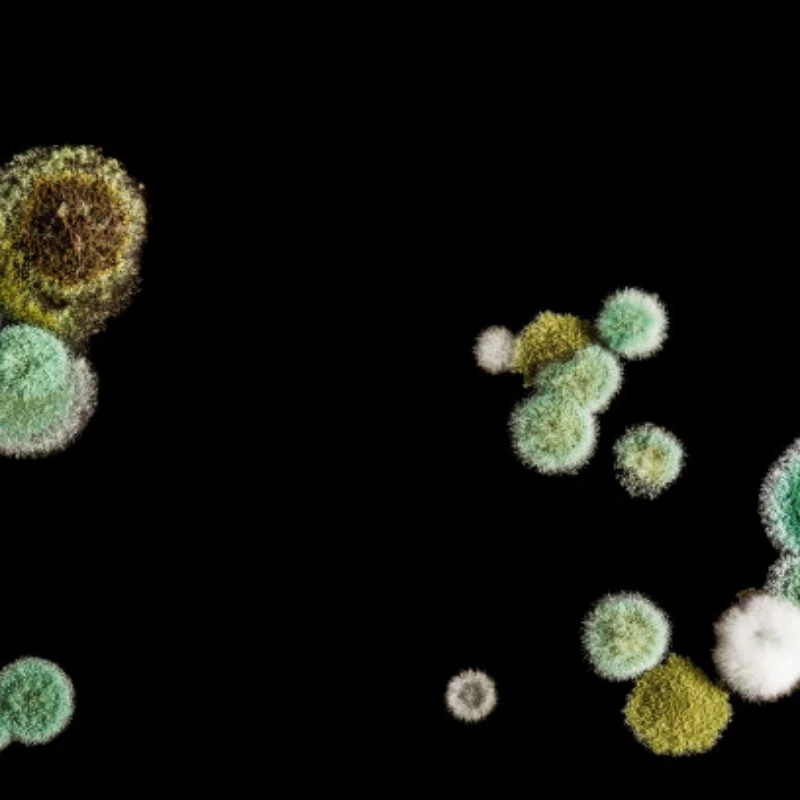
بكرة تفاضلية معدنية بكرة خزانة مختلفة لـ 1/10 Trxs Slash 4X4 Rustler 4X4 Stampede 4WD Hoss 4WD VXL RC قطع غيار السيارات

رخيصة بالجملة بكرة تفاضلية معدنية بكرة خزانة مختلفة لـ 1/10 Trxs Slash 4X4 Rustler 4X4 Stampede 4WD Hoss 4WD VXL RC قطع غيار السيارات. شراء مباشرة من موردي Shop1103750684 Store. استمتع بشحن مجاني في جميع أنحاء العالم! ✓ بيع لفترة محدودة ✓ إرجاع سهل.
اشترِ بكرة تفاضلية معدنية بكرة خزانة مختلفة لـ 1/10 Trxs Slash 4X4 Rustler 4X4 Stampede 4WD Hoss 4WD VXL RC قطع غيار السيارات من Shop1103750684 Store بسعر مناسب وجودة أفضل على ArabShoppy. يمكنك الحصول على 23% off وحفظ {save} عند شراء هذا العنصر ، لذلك ما عليك سوى دفع US $ 4.64 مقابل بكرة تفاضلية معدنية بكرة خزانة مختلفة لـ 1/10 Trxs Slash 4X4 Rustler 4X4 Stampede 4WD Hoss 4WD VXL RC قطع غيار السيارات. نحن نقدم مجموعة متنوعة من المنتجات المماثلة على موقعنا الإلكتروني ، بحيث يمكنك أن تجد بالضبط ما تبحث عنه ، حتى تلك التي لم تكن تعلم بوجودها من قبل. لدينا أيضًا مئات الصفقات على بكرة تفاضلية معدنية بكرة خزانة مختلفة لـ 1/10 Trxs Slash 4X4 Rustler 4X4 Stampede 4WD Hoss 4WD VXL RC قطع غيار السيارات من ArabShoppy ، دائمًا بأعلى جودة وأفضل ضمان. بالإضافة إلى ذلك ، يمكنك الاختيار بين النطاق السعري أو العلامة التجارية أو المتطلبات التي تعتقد أنها الأكثر أهمية لمنتجك المفضل.

إذا كنت مهتمًا بمنتجات أخرى متعلقة بـ بكرة تفاضلية معدنية بكرة خزانة مختلفة لـ 1/10 Trxs Slash 4X4 Rustler 4X4 Stampede 4WD Hoss 4WD VXL RC قطع غيار السيارات ، فيمكنك العثور عليها جميعًا على ArabShoppy حيث لدينا أفضل النتائج لك لمشاهدتها ومقارنتها وشرائها! لا نقدم لك سعرًا اقتصاديًا ومنتجات عالية الجودة فحسب ، بل نرغب ، ArabShoppy ، في مطابقة قراراتك ومساعدتك في شراء بكرة تفاضلية معدنية بكرة خزانة مختلفة لـ 1/10 Trxs Slash 4X4 Rustler 4X4 Stampede 4WD Hoss 4WD VXL RC قطع غيار السيارات حتى لا يفوتك أي شيء. ما عليك سوى النقر فوق الزر "اطلب الآن" أعلاه للحصول على مزيد من المعلومات حول منتجنا.